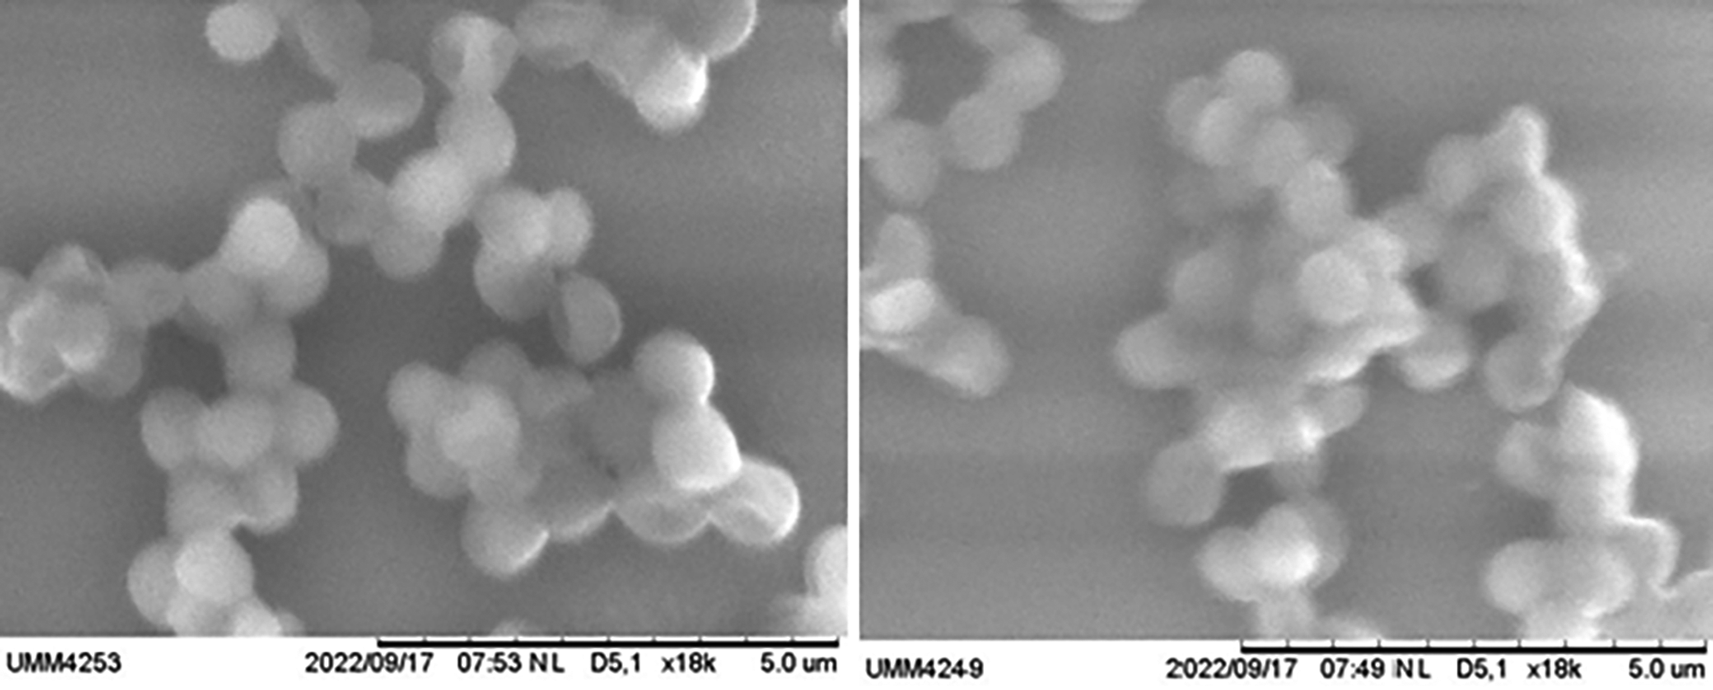

Keywords
ZnO-NP suspension, Wound Irrigation, Staphylococcus aureus, Biofilm, Infection After Fracture Fixation
This article is included in the QUVAE Research and Publications gateway.
This article is included in the Nanoscience & Nanotechnology gateway.
ZnO-NP suspension, Wound Irrigation, Staphylococcus aureus, Biofilm, Infection After Fracture Fixation
Infection after fracture fixation (IAFF) related to an implant in orthopaedic surgery is a commonly feared complication, resulting in non-union, poor functional outcome until loss of function, amputation, and even mortality and morbidity to the patient.1,2 This complication also carries a meaningful socioeconomic burden because treatment takes a long time and has high cost.3 Staphylococcus aureus is the most common cause of surgical site infection.4 Surgical site infection occurs because the microorganisms and dead tissue debris attached to the wound surface form biofilms. The formation of biofilm and the resistance of the microorganisms that form it to antimicrobials cause this process to continue into IAFF. Furthermore, the biofilm formation on the implant surface increases the difficulty of treatment.5 Therefore, the prevention of surgical infection becomes essential.
Intraoperative wound irrigation is one of the most important procedures for infection prevention. Normal saline is the most popular option because it is safe and acts as a diluent agent. However, normal saline does not have an antiseptic effect, so it cannot eradicate bacteria.6–8 Another option is povidone-iodine as an effective antiseptic. Unfortunately, an in vitro study showed that povidone-iodine could be toxic even at small concentrations and exposure duration of 1 minute.9 Because of the importance of intraoperative wound irrigation for infection prevention, a safe (non-toxic) and effective antiseptic solution is required.
Zinc oxide, especially in the form of a nanoparticle (ZnO-NP) suspension, appears to be very promising as a choice of intraoperative wound irrigation compared to non-antiseptic normal saline and toxic povidone-iodine.10 ZnO-NP is an effective antimicrobial material that damages the cell membrane of bacteria. Conversely, ZnO-NP is categorized as a safe substance to consume by the American Food and Drug Administration (FDA).11 This study aims to reveal more about the antibacterial effect of ZnO-NP suspension, particularly Staphylococcus aureus and its biofilm, in preventing surgical infection.
This research was conducted between June and December 2022 at the Laboratory of Clinical Microbiology, Faculty of Medicine, Universitas Brawijaya – Clinical Microbiology Installation of Dr. Saiful Anwar General Hospital.
An in vitro experimental study with a posttest-only control group design was used to see the antimicrobial activity and inhibitory effect of Staphylococcus aureus biofilm formation between a 20% ZnO-NP suspension (20 mg/mL) and compared to 0.3% povidone-iodine solution as the positive control.
The sample of this study is an isolate of Staphylococcus aureus bacteria obtained from the clinical isolate in the Clinical Microbiology Laboratory, Faculty of Medicine, Universitas Brawijaya. The isolate was stored in temperature -20°C in Tryptic Soy Broth media (TSB – Merck 105459).
Identification of Staphylococcus aureus bacteria
The procedure used for the identification of Staphylococcus aureus was Gram staining. In this study, the isolate used was Staphylococcus aureus. Furthermore, the identification and test of antimicrobial sensitivity with the Vitek® 2 system method were carried out. The procedure used for gram staining is listed below:
1. Glass objects (GEA 7105) were cleaned with cotton swab (Onemed size S) and passed over fire to remove fat or other substances, then left to cool for a while.
2. The bacterial preparation was made on a glass object with one inoculation, allowed to dry in air, then fixed on a Bunsen lamp.
3. The preparation was poured with crystal violet solution (Sigma-aldrich V5265), after one minute, the preparation was rinsed with water.
4. A Lugol solution (MERCK 1.09261.1000) was poured into the preparation, after one minute, the preparation was rinsed with water.
5. A 90% alcohol was poured into the preparation and rinsed with water after 5-10 seconds.
6. After that, a safranin (Sigma-aldrich 94635) was poured into the preparation, after 30 seconds, rinsed with water.
7. The preparation was dried with blotting paper (Ahlstrom-Munksjö Grade 240), then viewed under a light microscope (Olympus CX-21, USA) with 1000× magnification. It shows round purple and clustered bacteria identified as gram-positive cocci.
After gram staining, the preparation was identified as gram-positive cocci, an antimicrobial sensitivity was performed using the Vitek® 2 system (Biomérieux, USA). It was a system to identify bacteria isolates using GP ID cards with faster and accurate bacterial identification.
Bacterial inoculation in nutrient agar plate (NAP)
Staphylococcus aureus bacterial suspension was inoculated and placed in an incubator (Digisystem DSI-500D) that has been set for 24 hours at 37°C on Mueller-Hinton agar media (Sigma-aldrich 70191) to obtain separate colonies with four suspensions. The targeted bacterial concentration was 5 × 105 colony forming unit per millilitre (CFU/mL).
Antimicrobial susceptibility test of ZnO-NP suspension and 0.3% povidone-iodine solution using broth dilution method
The broth dilution method was used to assess the antibacterial activity, minimum inhibitory concentration (MIC) and minimum bactericidal concentration (MBC), of various antiseptic solutions. The principle of the broth dilution method is to expose the bacteria to be tested with a certain substance (in this study, an antiseptic solution). In general, the concentration of the solution used is a serial dilution multiple of two (2, 4, 6, 8, 10, 12, 14, 16 (μg/mL)). The first MIC value is the lowest ZnO-NP concentration, indicating a clear suspension. All 32 samples bacterial suspensions of various concentrations (2, 4, 6, 8, 10, 12, 14, 16 (μg/mL)) of ZnO-NP with four replication of each, were inoculated on Mueller Hinton agar and incubated at 37°C for 24 hours in an incubator that has been set (Digisystem DSI-500D) to determine the MBC value of ZnO-NP against Staphylococcus aureus. The MBC value is obtained when all bacteria are killed.
Biofilm identification
Biofilm formation was evaluated by inoculating Staphylococcus aureus bacteria cultured overnight plus tryptic soy broth (TSB – Merck 105459) into microwell in congo red agar plate. The congo red agar was made by infusing the congo red dye into mannitol salt agar (oxoid). After incubating for 24 hours at 37°C, the medium was rinsed twice using phosphate-buffered saline (PBS – Sigma-aldrich P4474) and then dried. The formation of biofilms is considered positive when a layer of violet crystalline colour appears on the walls and base of the tube, and the observation can be done by naked eye. The formation of rings at the level of the surface of a liquid is not considered meaningful in the formation of biofilms. MBIC from ZnO-NP suspension was assessed by evaluating biofilms formed on the surface of the microwell wall. Using the same method as the method for assessing the formation of biofilms, before incubation, a certain concentration of ZnO-NP suspension is added (1, 2, 3 μg/mL). Each concentration represents the intervention groups, rather than positive and negative control. A 1 μg/mL concentration of ZnO-NP suspension for group micro 1, 2 μg/mL concentration of ZnO-NP suspension for group micro 2 and 3 μg/mL concentration of ZnO-NP suspension for group micro 3. The ZnO-NP concentration is distinguished for the categorization of intervention groups. Then after the incubation is completed, staining is carried out, and the formed biofilm is evaluated using a scanning electron microscope (SEM - SU8600 Hitachi Europe) and based on optical density (OD) determined by an ELISA reader (Accuris Smartreader 96-T) with a wavelength of 630 nm (OD 630 nm). The lowest concentration that causes inhibition of biofilms on the surface of the microwell wall is considered to be MBIC. Meanwhile, concentrations without biofilm growth are considered minimum biofilm eradication concentration (MBEC) values.
Biofilm assay
Isolates from the microbiology lab, with a glucose TSB of 1% (Merck 105459). 200 μl or 0.2 ml of diluted suspension was added to 96 sterile microtiter wells. A total 20 wells were filled, 4 to each group negative control (A1-A4), positive control (A5-A8), micro 1 (A9-A12), micro 2 (B1-B4) and micro 3 (B5-8). After that, a suspension of ZnO-NP is added: 1 μg/mL to group micro 1, 2 μg/mL to group micro 2, and 3 μg/mL to group micro 3. Then incubated for 24 hours at a temperature of 37°C; after incubation, the suspension was removed, and the microtiter well was washed 3× with 0.2 ml sterile PBS pH 7.2 to remove planktonic cells (freeform). The biofilm formed at the wall or bottom of the well is stained with 1% violet crystals and left for 20 minutes. After that, 1 molar 200 μg hydrochloric acid (HCl) in concentrated isopropanol was added. The excess violet crystals are washed with water, the microtiter wells are then dried in an inverted position. Biofilm formation was assessed based on OD determined by an ELISA reader with a wavelength of 630 nm (OD 630 nm).
To evaluate the effect of various ZnO-NP suspension concentrations on the growth of colonies of Staphylococcus aureus bacteria, SPSS 25 (IBM Corp. 2017) (RRID:SCR_002865) for Windows statistical test program was used. Data distribution was tested for normality using the Shapiro-Wilk test, while homogeneity was tested using the Levene test. A comparison of the average number of colonies between 0.3% povidone-iodine and 20% ZnO-NP suspension has been done using an independent t-test.
The biofilm identification and assay result shows that data was not normally distributed and heterogenous; therefore, a Mann-Whitney test was used to determine the correlation between variables. The results of comparisons between groups were carried out with the Mann-Whitney test. It is statistically significance if the p-value < 0.05. All the statistical result from normality and homogeneity test to statistical data will be included in the underlying data.25
The experiment’s broth dilution method results showed that the MIC was at a concentration of 4 g/mL, where the black line began to appear and became clear in the test tube for ZnO-NP suspension. While the results of the colony forming unit (CFU) calculation and linear regression from serially increasing the dose of ZnO-NP at a concentration of 4 g/mL are shown in Table 1, and calculation results of methicillin-resistant Staphylococcus aureus (MRSA) colonies on Mueller–Hinton media with exposure to ZnO-NP suspension compared with 0.3% povidone-iodine are shown in Table 2.
The results of bacterial inoculation on Mueller–Hinton above show that the larger the dose, will decrease the number of bacteria (CFU). The dosage of MIC (4 g/mL) showed a decrease in CFU of as much as 99.3%, and a dose of 16 g/mL could eradicate all bacteria. In addition, the dose of 16 g/mL is the MBC. After all those procedures, the average number of colonies was compared. The independent t-test showed a significant difference between the number of colonies formed on the ZnO-NP 4 g/mL administration and 0.3% povidone-iodine (p-value = 0.001). Using 0.3% povidone-iodine causes bacteria not to grow at all. Similarly, administering ZnO-NP solution with a 16 g/mL concentration also caused no bacterial growth. Thus, the MBC concentration of ZnO-NP suspension had the same effect as 0.3% povidone-iodine administration. Biofilm identification was carried out in Congo Red agar to obtain a biofilm image with a picture of a black colony.
Analysis of the effect of ZnO-NP suspension in inhibiting the growth of biofilm-producing Staphylococcus aureus by SEM examination. SEM examination was carried out to qualitatively determine biofilms’ formation in Staphylococcus aureus bacteria. The formation of biofilms can be seen from the matrix extracellular of the biofilms formed and seen in SEM. SEM examinations were performed on negative, positive, and treatment groups (Figures 1 and 2).

This study found that the picture of biofilm formation in the treatment group was less compared to the control group (+). Coupled with the increased dose of ZnO-NP application to colonies of Staphylococcus aureus bacteria, there is less and less biofilm formation. MBIC was seen at a concentration of ZnO-NP suspension of 2 μg, while at higher doses, it showed lysis of bacterial cells.
Descriptive analysis is used to find out an overview of the purchasing variables. This descriptive analysis is expected to provide an overview of the state of patient data. To find out the description for each variable can be seen in Table 3.
| N | Mean ± SD | |
|---|---|---|
| Negative control | 4 | ‐0.547 ± 0.056 |
| Positive control | 4 | ‐0.301 ± 0.039 |
| Group 1 μg | 4 | ‐0.252 ± 0.011 |
| Group 2 μg | 4 | ‐0.247 ± 0.026 |
| Group 3 μg | 4 | ‐0.230 ± 0.009 |
The Mann-Whitney test was used to determine significant differences between the treatments with ordinal data scales or data that do not meet the assumptions of normality and homogeneity. Further analysis was carried out using Kruskal Wallis to test whether significant differences exist between one treatment group and another.
Based on the results of the Mann Whitney’s analysis in Table 4, it was found that the p-value for OD was 0.003, the result of the p-value < 0.05 for the OD parameter, which means that there is a significant difference between the treatments at an error rate of 5%. Testing to determine the differences between each group used the Kruskal-Wallis test. The results of the comparison between each group were carried out in Table 5, showing a significant difference in the average group if the p-value < 0.05.
Staphylococcus aureus is a gram-positive bacteria that can cause various diseases. Infection by this pathogen is common both in the community and in hospitals. Staphylococcus aureus is also a bacterium that often causes infections in bones and joints.12 Zinc oxide nanoparticle (ZnO-NP) is a white to yellowish-white crystalline powder which are soluble in water. The most common crystal structures are wurtzite (hexagonal) and zinc alloys. The physico-chemical properties of ZnO-NP contribute to its antibacterial activity.13
This study proves that ZnO-NP suspension has antibacterial activity with MIC at 4 g/mL, effectively killing 99.3% of bacteria. In a maximal dose of 16 g/mL, ZnONP suspension killed 100% bacteria. Based on Table 2 above, in 2 g/mL, CFU count 1.9 × 108; in 4 g/mL, the CFU decreases to 2.5 × 105. For dose 16 g/mL, the CFU is 0, the same as 0.3% povidone-iodine. This study’s MBC had a killing power equivalent to that of diluted 0.3% povidone-iodine. A diluted povidone-iodine solution has been recommended for wound irrigation.14 This study shows that ZnO-NP is a potential antiseptic agent and can provide an effect equivalent to other recommended antiseptic solutions.15 On the other hand, there are significant differences in MBC values from those found in this study compared to previous studies. In this study, the MBC value obtained from the experiment was 16 g/mL, this was 7.81 g/mL in previous studies, reaching 50% of this study.16 In contrast, the studies above on poultry feedstuffs showed MBC as high as 100 g/mL. This difference could be caused by differences in the isolates used.
There are several antibacterial mechanism of ZnO-NP: (1) the release of ROS reactive oxygen species (ROS) generated on the surface of nanomaterials can attack the bacterial cell wall, and the antibacterial activity is further enhanced by increasing the surface area17; (2) another possible mechanism for the antibacterial activity of ZnO is the release of Zn2+ ions which can damage cell membranes and penetrate intracellular contents17; (3) Contact between bacterial cells and particles causes changes in the microenvironment within the contact area of organisms and particles. Brayner et al. also showed that the bacterial cell wall was damaged and disorganized after contact with ZnO-NP nanoparticles. The abrasive ZnO-NP causes an increase in membrane permeability leading to the subsequent cellular internalization of the nanoparticles18 and; (4) other mechanisms. It is also believed that the antimicrobial activity of ZnO may be related to its photocatalytic activity. By absorbing UV light which activates its interaction with bacteria, suspension of ZnO nanoparticles can produce ROS such as H2O2, which has a phototoxic effect on bacteria.19
ZnO-NP has been developed for research purposes and health-related applications. Not only does it have antibacterial activity, but ZnO-NP inhibits biofilm formation.19 Based on SEM and OD in this study, MBIC is at a dose of 2 μg/mL and is statistically significant. While bacteriolysis effectively started at a dose of 3 μg/mL. Research conducted by Abdelraheem also found the same thing. ZnO-NP was found to suppress the expression of the ica A, ica D, and fnb A genes, the main genes forming biofilms in Staphylococcus aureus.19 Based on the study’s results, it was used as a background to assess the ability of ZnO-NP to inhibit the formation of biofilms against Staphylococcus aureus bacteria. In research by Jasim and Abdelraheem, it was also explained that ZnO-NP is effective in inhibiting the formation of biofilms in Vancomycin and Linezolid-resistant Staphylococcus aureus so that it can also be used on multi-resistant Staphylococcus aureus against antibiotics.19,20 In another study by Abdulkareem, ZnO-NP was also used in dental implants and had benefits in antimicrobials and inhibition of biofilm formation.21
ZnO-NP has several mechanisms that inhibit biofilm formation: (1) inhibiting the adhesion and proliferation stages; (2) changing the formation of amyloid fibrils; and (3) inhibiting the Quorum sensing mechanism, which is not yet known in detail. The workings of ZnO-NP suspension are thought to have started by degrading biofilms with an effective dose of 2 μg/mL, and then after the biofilm is destroyed, the bacterial cells die with a higher dose. Without biofilms, bacteria become more susceptible to antibacterials agents.22–24
20% ZnO-NP suspension is a promising solution for preventing surgical infection due to its antibacterial and antibiofilm effects. It has a minimum inhibitory concentration (MIC) for Staphylococcus aureus at 4 g/mL and a minimum bactericidal concentration (MBC) at 16 g/mL. A higher suspension dose effectively eradicates Staphylococcus aureus bacteria and its biofilm, which has minimal biofilm inhibitory concentration (MBIC) at a dose of 2 μg/mL. This study has limitations because it does not evaluate the expression of genes that form Staphylococcus aureus biofilm formation; therefore, further research is needed.
Krisna Yuarno Phatama: Conceptualization, Writing – Original Draft Preparation, Validation, Project Administration, Methodology
Respati S. Dradjat: Conceptualization, Writing – Original Draft Preparation, Supervision
Edi Mustamsir: Conceptualization, Writing – Original Draft Preparation, Supervision
Dwi Yuni Nurhidayati: Supervision, Validation, Data Curation, Resources
Dewi Santosaningsih: Supervision, Validation, Data Curation, Resources
Dwikora Novembri Utomo: Writing – Review & Editing, Supervision, Validation
Mohamad Hidayat: Writing – Review & Editing, Supervision, Validation
Some data underlying the results are available as part of the article, and the others are available on the list of additional resources below.
Zenodo: Suspension of Zinc Oxide Nanoparticles (ZnO-NP) as an Intraoperative Wound Irrigation to Prevent Infection After Fracture Fixation, https://doi.org/10.5281/zenodo.7765281. 25
This project contains the following underlying data:
- Raw Data Fixed.xlsx
- Descriptive ZnO-NP & PI CFU.xlsx (Descriptive comparative CFU between ZnO-NP and PI)
- Descriptive OD.xlsx (Descriptive Optical Density of Biofilm)
- Normality & Homogeneity Test.xlsx
- Statistical Test.xlsx (Mann-whitney & Kruskal-wallis test)
- Control Negative - UMM4247(x18k).jpg (SEM)
- Control Negative - UMM4247(x18k).txt (SEM)
- Control Negative - UMM4248(x18k).jpg (SEM)
- Control Negative - UMM4248(x18k).txt (SEM)
- Control Positive - UMM4249(x18k).jpg (SEM)
- Control Positive - UMM4249(x18k).txt (SEM)
- Control Positive - UMM4250(x18k).jpg (SEM)
- Control Positive - UMM4250(x18k).txt (SEM)
- Micro 1 - UMM4251(x18k).jpg (SEM)
- Micro 1 - UMM4251(x18k).txt (SEM)
- Micro 1 - UMM4252(x18k).jpg (SEM)
- Micro 1 - UMM4252(x18k).txt (SEM)
- Micro 1 - UMM4253(x18k).jpg (SEM)
- Micro 1 - UMM4253(x18k).txt (SEM)
- Micro 1 - UMM4254(x18k).jpg (SEM)
- Micro 1 - UMM4254(x18k).txt (SEM)
- Micro 2 - UMM4255(x18k).jpg (SEM)
- Micro 2 - UMM4255(x18k).txt (SEM)
- Micro 2 - UMM4256(x18k).jpg (SEM)
- Micro 2 - UMM4256(x18k).txt (SEM)
- Micro 2 - UMM4257(x18k).jpg (SEM)
- Micro 2 - UMM4257(x18k).txt (SEM)
- Micro 2 - UMM4258(x18k).jpg (SEM)
- Micro 2 - UMM4258(x18k).txt (SEM)
- Micro 3 - UMM4263(x18k).jpg (SEM)
- Micro 3 - UMM4263(x18k).txt (SEM)
- Micro 3 - UMM4265(x18k).jpg (SEM)
- Micro 3 - UMM4265(x18k).txt (SEM)
- Micro 3 - UMM4266(x18k).jpg (SEM)
- Micro 3 - UMM4266(x18k).txt (SEM)
Data are available under the terms of the Creative Commons Attribution 4.0 International license (CC-BY 4.0).
Zenodo: Suspension of Zinc Oxide Nanoparticles (ZnO-NP) as an Intraoperative Wound Irrigation to Prevent Infection After Fracture Fixation, https://doi.org/10.5281/zenodo.7765281. 25
This project contains the following reporting guidelines:
Data are available under the terms of the Creative Commons Attribution 4.0 International license (CC-BY 4.0).
| Views | Downloads | |
|---|---|---|
| F1000Research | - | - |
|
PubMed Central
Data from PMC are received and updated monthly.
|
- | - |
Is the work clearly and accurately presented and does it cite the current literature?
Partly
Is the study design appropriate and is the work technically sound?
Partly
Are sufficient details of methods and analysis provided to allow replication by others?
Partly
If applicable, is the statistical analysis and its interpretation appropriate?
Partly
Are all the source data underlying the results available to ensure full reproducibility?
Yes
Are the conclusions drawn adequately supported by the results?
Partly
Competing Interests: No competing interests were disclosed.
Reviewer Expertise: Orthopaedics and Traumatology, and Genetic
Is the work clearly and accurately presented and does it cite the current literature?
Yes
Is the study design appropriate and is the work technically sound?
Yes
Are sufficient details of methods and analysis provided to allow replication by others?
Yes
If applicable, is the statistical analysis and its interpretation appropriate?
Yes
Are all the source data underlying the results available to ensure full reproducibility?
Yes
Are the conclusions drawn adequately supported by the results?
Yes
Competing Interests: No competing interests were disclosed.
Reviewer Expertise: As a fellow orthopedic surgeon, this study helps provide an additional choice of antiseptic fluids to be used in cases of fractures that require fixation.
Alongside their report, reviewers assign a status to the article:
| Invited Reviewers | ||
|---|---|---|
| 1 | 2 | |
|
Version 2 (revision) 28 Sep 23 |
||
|
Version 1 26 May 23 |
read | read |
Provide sufficient details of any financial or non-financial competing interests to enable users to assess whether your comments might lead a reasonable person to question your impartiality. Consider the following examples, but note that this is not an exhaustive list:
Sign up for content alerts and receive a weekly or monthly email with all newly published articles
Already registered? Sign in
The email address should be the one you originally registered with F1000.
You registered with F1000 via Google, so we cannot reset your password.
To sign in, please click here.
If you still need help with your Google account password, please click here.
You registered with F1000 via Facebook, so we cannot reset your password.
To sign in, please click here.
If you still need help with your Facebook account password, please click here.
If your email address is registered with us, we will email you instructions to reset your password.
If you think you should have received this email but it has not arrived, please check your spam filters and/or contact for further assistance.
Comments on this article Comments (0)